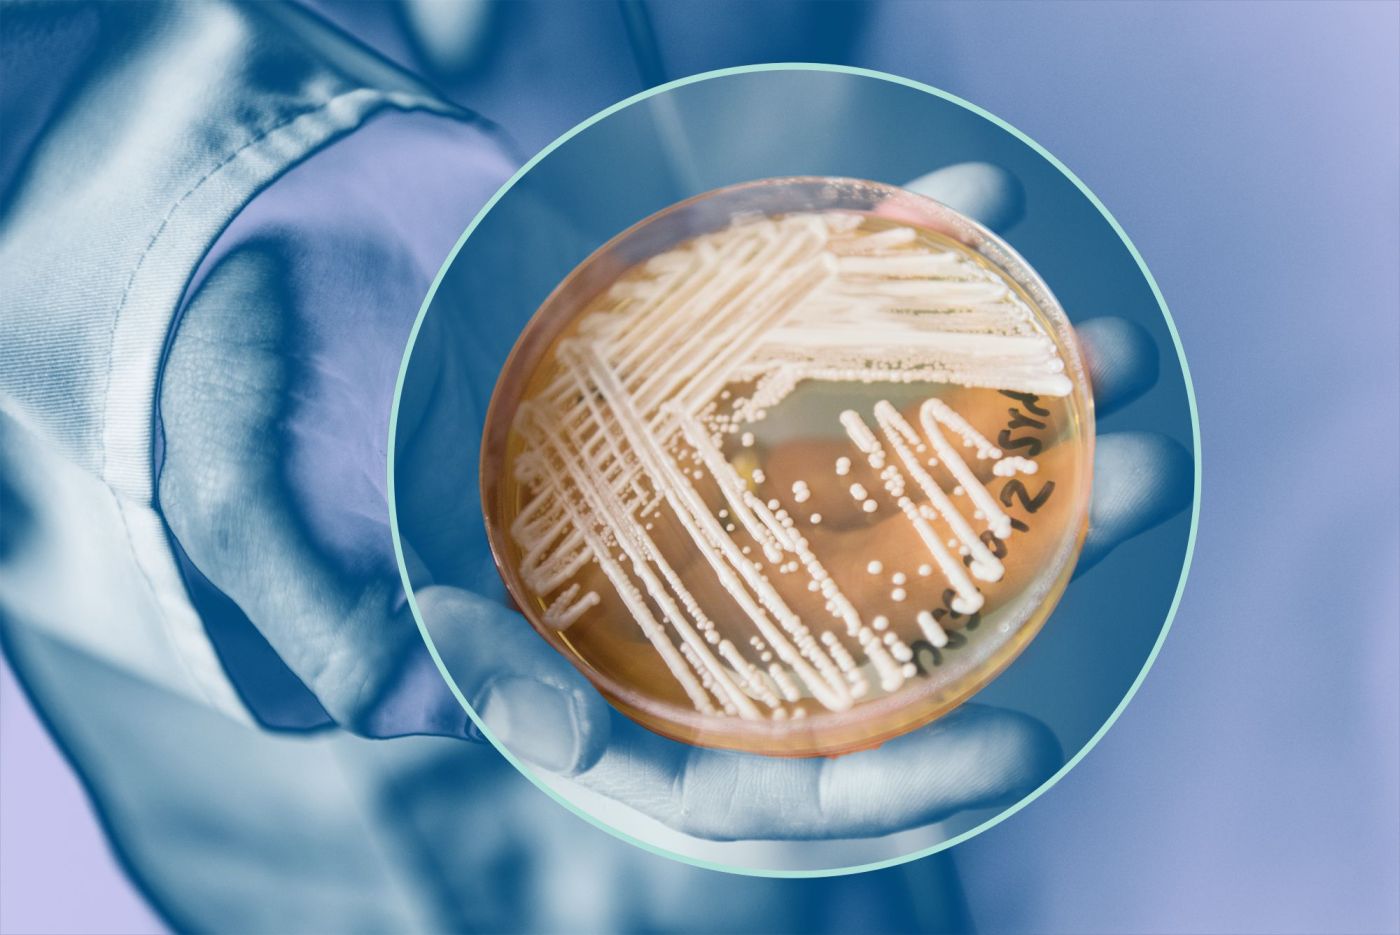

Απαντήσεις για την πανδημία, το μικρόβιο Candida Auris που απειλεί τα νοσοκομεία και την οξεία ηπατίτιδα που μολύνει παιδιά έδωσε η πρόεδρος της ΕΙΝΑΠ, Ματίνα Παγώνη, επισημαίνοντας ότι αυτό το καλοκαίρι θα πάμε καλά όσον αφορά τον ιό μιας και θα κινούμαστε κυρίως σε εξωτερικούς χώρους.
«Οι εσωτερικοί χώροι είναι εκεί που δημιουργούνται τα προβλήματα. Η μεταδοτικότητα στους εξωτερικούς χώρους είναι μειωμένη», πρόσθεσε η κ. Παγώνη.
Μετράει χρόνια η γνωριμία με το Candida Auris
Μιλώντας για το μικρόβιο που μολύνει ευάλωτους ασθενείς κατά της ασθενείας τους ανέφερε ότι οι γιατροί το γνωρίζουν πολλά χρόνια.
«Το γνωρίζουμε εδώ και πολλά χρόνια. Το 2008 εντοπίστηκε, με καλλιέργεια, στο αυτί ενός Ιάπωνα. Είναι από πολύ δυνατό στέλεχος, ιδιαίτερα μετά το 2011 σε ΜΕΘ και σε τμήματα του νοσοκομείου».
Σύμφωνα με την πρόεδρο της Ένωσης Ιατρών Νοσοκομείων Αθήνας – Πειραιά αυτό που έχει σημασία είναι «να το προλάβουμε γρήγορα για να δώσουμε την κατάλληλη θεραπεία. Το στέλεχος αυτό κάνει μεγάλη ζημιά σε ασθενείς που έχουν υποκείμενα νοσήματα».
Θέλοντας να καθησυχάσει τους πολίτες η κ. Παγώνη αποκάλυψε ότι τους τέσσερις τελευταίους μήνες στο νοσοκομείο όπου εργάζεται (σ.σ. στο νοσοκομείο Γεννηματάς) είχαν δέκα περιστατικά μόλυνσης, τα οποία όμως πήγαν πολύ καλά.
«Απομονώνεται ο ασθενής, καθαρίζεται ο χώρος πολύ καλά, γίνονται καλλιέργειες και μετά ξεκινάει η θεραπεία στον άρρωστο» επισήμανε η κ. Παγώνη, η οποία συσχέτισε την αύξηση των περιστατικών μολύνσεων με την πανδημία και τον μεγάλο αριθμό ασθενών.
«Δεν χρειάζεται πανικός. Χρειάζεται προσοχή» προσέθεσε. Απαντώντας στο εάν υπάρχει κίνδυνος να μολυνθεί κάποιος και να μεταφέρει το μικρόβιο εκτός νοσοκομείου η κ. Παγώνη ήταν αρνητική. Ωστόσο, όπως δήλωσε, χρειάζεται προσοχή στο προσωπικό που διαχειρίζεται τους ανθρώπους.
Tο pronews.gr δημοσιεύει κάθε σχόλιο το οποίο είναι σχετικό με το θέμα στο οποίο αναφέρεται το άρθρο. Ο καθένας έχει το δικαίωμα να εκφράζει ελεύθερα τις απόψεις του. Ωστόσο, αυτό δεν σημαίνει ότι υιοθετούμε τις απόψεις αυτές και διατηρούμε το δικαίωμα να μην δημοσιεύουμε συκοφαντικά ή υβριστικά σχόλια όπου τα εντοπίζουμε. Σε κάθε περίπτωση ο καθένας φέρει την ευθύνη των όσων γράφει και το pronews.gr ουδεμία νομική ή άλλα ευθύνη φέρει.
Δικαίωμα συμμετοχής στη συζήτηση έχουν μόνο όσοι έχουν επιβεβαιώσει το email τους στην υπηρεσία disqus. Εάν δεν έχετε ήδη επιβεβαιώσει το email σας, μπορείτε να ζητήσετε να σας αποσταλεί νέο email επιβεβαίωσης από το disqus.com
Όποιος χρήστης της πλατφόρμας του disqus.com ενδιαφέρεται να αναλάβει διαχείριση (moderating) των σχολίων στα άρθρα του pronews.gr σε εθελοντική βάση, μπορεί να στείλει τα στοιχεία του και στοιχεία επικοινωνίας στο info3@pronews.gr και θα εξεταστεί άμεσα η υποψηφιότητά του.